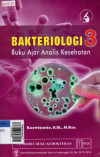
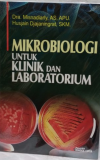

Found 6206 from collection database.
15
Must read articles
April 17, 2026
Terbaru :
- Hadiri Undangan Resmi Presiden Republik Indonesia, Ini Komitmen dan Rencana Tindak Lanjut Strategis Rektor Unidar Ambon - January 16, 2026
- Wujudkan Pendidikan Bermutu untuk Semua, Unidar Ambon Teken MoU bersama Dikbud Malteng, SEAMEO, FKIP Unpatti dan UBN - November 30, 2025
- Pendidikan Fisika Unidar Ambon Raih Akreditasi Baik Sekali - October 3, 2024
- Alhamdulillah, Unidar Ambon punya 2 Profesor Sekaligus - September 22, 2023
- Pesan Kabid Humas Polda Maluku, Kepada Maba Unidar Ambon - August 25, 2022